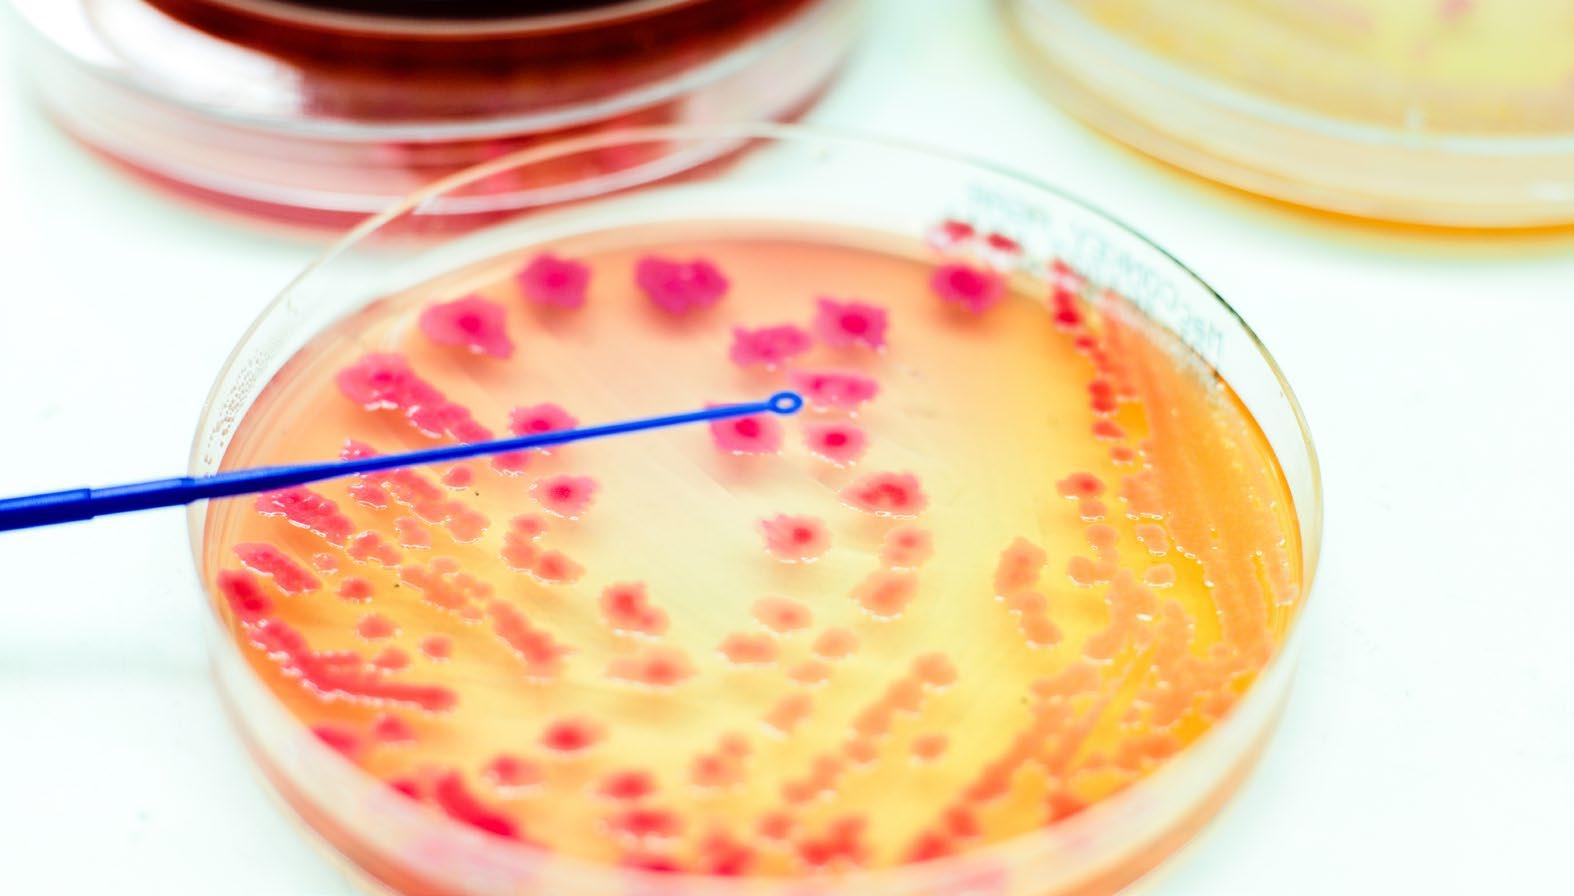
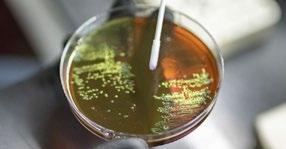

Medicine and Biomedical Sciences Study Day
St John’s College Oxford


![]()




Medicine and Biomedical Sciences Study Day
St John’s College Oxford


Founded in 1555 by Sir Thomas White, St John’s College is one of the larger of the 39 colleges that make up the University of Oxford. Like all colleges, it is an independent, self-governing establishment, which functions both as an academic institution and as a social and residential centre for its members. The College has around 650 undergraduate and postgraduate students, and around 100 academics.
Over the course of the day you will hear from academics and current medical students from St John’s College and gain an insight into what it’s like to study Medicine or Biomedical Sciences at university.
In this booklet you will find the programme and session resources, as well as support for using the skills and experience gained today in future applications.
We hope that you find the subjects as interesting and rewarding as our students do.

TIME SESSION
9:45 – 10:00
10:00 – 10:25
10:25 - 10:45
10:45 – 12:10
REGISTRATION
WELCOME TALK: INTRODUCTION TO THE EVENT & OXFORD EXPLAINED FOR MEDICINE AND BIOMEDICAL SCIENCES
Travis Wood & Jack Gamblin
WARM-UP ACTIVITY - Euan Warner & Arran Kinnear
LECTURE 1: THE SILENT PANDEMIC: ANTIBIOTIC RESISTANCE
Jack Gamblin
12:10 – 13:00 LUNCH
13:00 – 14:30
14:30 – 15:15
LECTURE 2: DR. ROBOT: ARTIFICIAL INTELLIGENCE IN HEALTHCARE
Travis Wood
PRESENTATION: CAREERS IN MEDICINE AND BIOMEDICAL SCIENCES ROUTES INTO MEDICINE AND BIOMEDICAL SCIENCES, CAREERS AVAILABLE, OXFORD GRADUATE DESTINATIONS
Rachel Walsh
15:15 – 15:35 BREAK
15:35 – 16:00
16:00 – 17:00
PRESENTATION: ENTRANCE EXAMS - UCAT & ESAT
ADMISSIONS WORKSHOP: APPLYING FOR MEDICINE & BIOMEDICAL SCIENCES
GROUP A: PERSONAL STATEMENTS - INTERVIEWS
GROUP B: INTERVIEWS - PERSONAL STATEMENTS (Groups will be allocated on the day and rotateeach segment lasts 30 minutes)
17:00 – 17:30 PANEL Q & A

The study day will be hosted on Zoom. Please click the link below to access the Zoom meeting. https://us06web.zoom.us/j/81476027236
Should this not work use the following to enter the meeting: ID: 814 7602 7236
Passcode: Inspire26
Vevox will be used as our live Q and A software. We encourage you to ask questions throughout the day, which will be monitored by a member of the team.
https://vevox.app/#/m/145321064
Session ID: 145-321-064
Passcode: Inspire2026
During the workshops we will be using breakout rooms and each student will be pre-assigned to a room. When the workshops begin, students will automatically receive a pop-up notification prompting them to join their designated breakout room.
For everyone’s safety and enjoyment, we ask that all attendees and participants abide by the following code of conduct during our event:
• Please enter your unique username which has been emailed to you, with no other personal or identifying information
If you do not use your unique username, you will be asked to leave the session and re-join.
• All messages should be respectful, and kind. Any inappropriate or offensive language will not be tolerated.
• Do not share any personal or identifying information (for example, your email address, mobile phone number or social media accounts).
• Please keep all questions / messages on topic, to avoid distracting the speaker and attendees.
• Cameras and microphones should be switched off for the main lectures. During the breakout rooms both can be used for an interactive experience.
If you do not abide by this code of conduct, you may be removed from the event, either temporarily or for the remainder of the event. A parent / guardian and/or your school may be informed. Misuse of the Q&A or chat may result in some or all functionalities being disabled.
10:45 – 12:10
LECTURE 1: THE SILENT PANDEMIC: ANTIBIOTIC RESISTANCE
Jack Gamblin
These activity sheets contain questions and tasks to think about during the lecture. You will be able to share your thoughts in the chat during the discussion afterwards.
Imagine you are a GP seeing a patient who takes daily antibiotics “to get a head start against bacteria” despite having no clinical indication. What key points would you explain to promote antibiotic stewardship and reduce the development of antimicrobial resistance (AMR)?
Design a study to assess the impact of public health campaigns on the incidence of antibiotic-resistant bacterial infections in the UK.
• What are the main research questions?
• How would you account for differences by:
o Urbanicity
o Educational attainment
o Socioeconomic status
o Age
o Race/ethnicity
• What are the challenges with this type of study and how can we overcome these?
• If you were the Government, how would you convince pharmaceutical companies to invest in antibiotic research and development?
• Discuss the challenges that will present in terms of funding sources for this and equitable resource allocations
RESOURCES:

13:00 – 14:30
LECTURE 2: DR. ROBOT – ARTIFICIAL INTELLIGENCE IN HEALTHCARE
Travis Wood
These activity sheets contain questions and tasks to think about during the lecture. You will be able to share your thoughts in chat during the discussion afterwards.
You are a doctor in a busy hospital. A new AI system, Dr. Robot, gives you real-time recommendations about patient treatment. The AI has been trained on millions of cases worldwide and often predicts outcomes better than humans:
• If Dr. Robot recommends a treatment you wouldn’t normally choose, would you follow it? Why or why not?
• At what level of accuracy would you feel confident enough to use your AI in real patients?
• What information about the AI model would you want to know before using its recommendations in your decisionmaking?
Communicating AI to patients:
• How should doctors communicate AI recommendations to patients?
• How would you handle a patient who is sceptical of AI?
Consider:
• Which areas in healthcare do you think we should invest the most resources in developing AI for? Why?







We’ve prepared a range of follow-up resources to help you build on your experience today and apply it in applications, cover letters and CVs.
CLICK HERE TO ACCESS FURTHER
15:35 – 16:00
Why do you want to study this course or subject?
My decision to study medicine stems from my deep interest in human biology, with a particular fascination with immunology, public health and the cardiovascular system. Becoming a doctor is not a decision I have taken lightly; the rigorous nature of the medicine course will prepare me for a successful career as a doctor.
During a residential at Oxford University, I took part in a taster seminar about the development of vaccines for tuberculosis in African countries with limited health infrastructure. This fuelled my interest in global public health, recognising that a medicine degree will lead to a career in which I can have both a local and global impact in defending everyone’s right to healthcare.
I EXPLORED THE USE OF STENTS IN THE TREATMENT OF CORONARY HEART DISEASE AND ATTENDED A LECTURE AT THE UNIVERSITY OF BIRMINGHAM THAT EXAMINED THE DIFFERENCES BETWEEN ANGIOPLASTY AND STENT INSERTION
How have your qualifications and studies helped you prepare for this course or subject?
In addition to my four A levels, I am undertaking an EPQ in which I investigated the handling of the first coronavirus wave in England, focusing on the oftenoverlooked treatment of elderly patients’ mental health within the social care system. Throughout the project, I became particularly interested in how personal biases can influence decision-making in medicine. A recent journal article highlighted differing perspectives between the Health Secretary and frontline general practitioners regarding the allocation of resources in elderly patient care during the pandemic. This reinforced for me the ethical dilemmas that can arise in medicine, especially when difficult decisions must be made beyond practitioners’ control.
I have developed a particular interest in cardiovascular medicine through my study of the cardiovascular system in A level Biology. To deepen my understanding, I explored the use of stents in the treatment of coronary heart disease and attended a lecture at the University of Birmingham that examined the differences between angioplasty and stent insertion, particularly in relation to patient recovery and long-term outcomes.
What else have you done to prepare outside of education, and why are these experiences useful?
A work placement in A&E gave me a direct understanding of the ‘frontline’ nature of the profession. I assisted nurse practitioners in the ‘minors’ unit of A&E by putting on casts, showing patients to the X-ray rooms, and examining radiography images. The compassion shown to patients and the commitment to quality of care, despite long hours and busy schedules, broadened my understanding of the six NHS values and their significance in practice.
I have volunteered in community projects at my local church, running weekend sessions for children, providing food to families eligible for free school meals during the holidays, and, more recently, helping to clean the church to maintain a clean, safe and comfortable environment for vulnerable parishioners. These roles have taught me a lot about communication and having empathy with people of all ages and backgrounds. I have also worked within teams, training new volunteers and assigning roles suited to their skills and experience.
My passion for the sciences, particularly human biology, and my compassionate nature will position me for a successful career in this field.
– 16:00 PERSONAL
Why do you want to study this course or subject?
The ability to heal is initially what attracted me to medicine. Ironically, the first patient I encountered during work experience was one the doctor was unable to heal - a terminally ill lady whose metastatic tumours gave her only weeks to live. Rather than dishearten me, I was encouraged by how the doctor eased the distress of the situation through sensitive communication and provision of appropriate palliative care to ensure patient comfort. The level of empathy witnessed not only cemented my desire to pursue medicine but also inspired the quality of care I would wish to embed into my own practice.
THE OPPORTUNITY FOR CONTINUAL LEARNING AND THE SATISFACTION OF PROVIDING COMFORT DRIVE ME TO PURSUE THIS PROFESSION, DESPITE ITS DEMANDS.
How have your qualifications and studies helped you prepare for this course or subject?
My love for science and its practical applications in relation to the human body spurs my decision to study medicine. In A-level Biology, I enjoy relating chemical principles to explain metabolic pathways and cell function. Reading Watson’s “DNA” extended my knowledge of genetics and stimulated thoughts on the ethics of controversial topics like genetic screening for disease. Science practicals have made me a more methodical planner and sharpened my attention to detail. In Maths, my Gold Awards in UKMT challenges demonstrate the aptitude for problem solving, a key skill in patient diagnosis. Economics strengthens my data analysis abilities, useful whilst conducting my EPQ on the feasibility of malaria eradication, a topic led by an article in “New Scientist”. The research heightened my awareness of how anti-microbial resistance is a globally increasing threat to our ability to combat infection. Gaining an academic scholarship and school
“Outstanding Achievement” awards show my dedication to maintain high work standards.
What else have you done to prepare outside of education, and why are these experiences useful?
Various work experiences gave me insight into the realities of a medical career. In the hospital setting, I saw how the on-call team’s collaborative efforts enabled them to cope under time pressure during a high patient intake. I recognised that effective communication with patients and among professionals was vital in providing quality care. It was exciting to consolidate theoretical knowledge of the heart by listening to heart sounds, interpreting ECGs, and identifying atrial fibrillation. I appreciated the difficult dilemmas doctors face when a consultant I shadowed had to decide whether to pursue aggressive treatment in a frail patient with emboli and an aneurysm.
I contribute to the wider community by volunteering at a care home and working for Kumon to support children in their studies. Having built relationships with care home residents over the past year, I admire their resilience in coping with ageing and find it rewarding to make a difference through companionship and daily support. Working with different age groups has required patience, adaptability and the ability to explain concepts clearly.
I recognise the importance of work-life balance to stay energised and alert. I am currently a black belt in karate after ten years of training; facing opponents has made me a more strategic thinker, able to make quick decisions under pressure. I enjoy group work and have represented my school in team events, most recently Young Enterprise, where I learned to manage resources and present ideas effectively. Roles as Student Librarian and Senior Prefect have developed my leadership skills through organising activities and coordinating duties.
The opportunity for continual learning and the satisfaction of providing comfort drive me to pursue this profession, despite its demands. I believe my intellectual and personal qualities, strong work ethic and enthusiasm will place me in good standing on a medical course and in my future career.
15:35 – 16:00 PERSONAL STATEMENTS
Why do you want to study this course or subject?
What is death? Exploring this question, which sits at the intersection between medical science and society, has affirmed my commitment to study medicine. Through weekly volunteering on the inpatient ward desk at Hospice in the Weald, I discovered how medical science, law and socio-cultural values converge in end-of-life care. To deepen my understanding of how modern clinical criteria for diagnosing death were developed, I read an article in the British Journal of Anaesthesia, which I later presented to my school medical society.
Listening to the thoughts and fears of patients and their carers has been humbling, underscoring the importance of comfort and dignity in palliative care. Speaking to a patient with end-stage liver disease in A&E made me appreciate the demand for organ transplants and the ethical implications of resource scarcity. I read about trials extending the pool of viable organs through interventions following organ recovery and visited a research centre, where I was struck by the collaboration between surgeons and immunologists in normothermic machine perfusion trials. This reinforced my appreciation of how clinician scientists translate research into evidence-based practice.
At a lecture on HIV, I asked about the use of monoclonal antibodies to diversify prophylactic therapies. This led me to explore existing treatments such as reverse transcriptase inhibitors and the role of systematic reviews in advocating pre-exposure prophylaxis for at-risk groups. I am motivated by medicine’s ability to unite scientific innovation, ethical reasoning and compassionate care.
How have your qualifications and studies helped you prepare for this course or subject?
My interest in anatomy led me to visit a plastination museum where, as a keen pianist, I appreciated the denser vasculature at the fingertip relative to the rest of the finger. At the national finals of the British Biology Olympiad, I refined my manual dexterity by dissecting blowfly larvae under a microscope, minimising tissue damage to ensure drugs could be delivered to a beating heart.
To gain further insight into clinical practice, I arranged work experience across multiple specialities. Observing
a registrar discuss a surgical procedure with a patient highlighted the collaborative nature of decision-making and informed consent. During a vascular multidisciplinary team meeting, a consultant emphasised that a patient preferred the term “operated leg” to “stump”, demonstrating the power of language in medical communication.
Through handling out-of-hours enquiries from hospice patients in the community, I became more aware of the
I AM
MEDICINE’S ABILITY
challenges of accessing healthcare resources and the importance of empathy, particularly when supporting recently bereaved callers. These academic and clinical experiences have strengthened my analytical skills, scientific curiosity and appreciation of patient-centred care.
What else have you done to prepare outside of education, and why are these experiences useful?
Through tutoring music theory to children of varying ages, I have learnt to build rapport and tailor my communication style to each individual. Playing violin as co-leader of the Kent County Youth Orchestra, I collaborated with musicians across disciplines to perform under pressure and create a unified sound, developing teamwork and resilience.
As Head Boy, I spoke in assembly about cortisol physiology, empowering peers to recognise the physical symptoms of stress. Balancing academic commitments, leadership responsibilities, and musical pursuits has strengthened my organisational skills and self-discipline, which are essential for maintaining wellbeing in demanding environments. These experiences have prepared me for medicine as both an intellectually rigorous discipline and a caring vocation, where I will continue to develop my scientific knowledge, empathy and teamwork skills.
Browse the University of Oxford’s first digital prospectus.
Still have questions? Check out the links on this page to a range of websites with further information or if you have any more questions, please don’t hesitate to get in contact with us:
inspire@sjc.ox.ac.uk
access@sjc.ox.ac.uk

Oxplore is an engaging digital resource from the University of Oxford. As the ‘Home of Big Questions’, it aims to challenge those from 11 to 18 years with debates and ideas that go beyond what is covered in the classroom. Big questions tackle complex ideas across a wide range of subjects and reflect the kind of critical thinking students undertake at university.
Discover your new favourite topic with our Springboard videos, bringing you cutting-edge research from Oxford’s graduate students on topics from climate change and colonialism to microbiomes and mathematical logic. These videos are intended for school pupils in Years 11, 12 and 13. Each offers an introduction to a new topic, plus lots of activities and further resources to explore.
See how else Oxford can support can support your application by looking at the Oxford Outreach Calendar.


St John’s College

